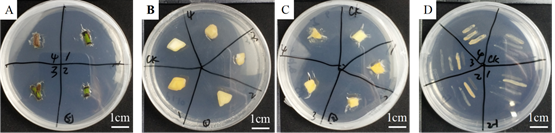

eISSN: 2576-4462


Research Article Volume 6 Issue 1
1Institute of Horticultural Biotechnology, Fujian Agriculture and Forestry University, Fuzhou, 350002, China
2Jinan PhytoRTD Eco-Engineering Co. Ltd, Jinan, 250100, China
3Dezhou PhytoRTD Ecology Co. Ltd, Dezhou, 253076, China
4ianou PhytoRTD Eco-Agriculture Co. Ltd, Jianou, 353111, China
5Fujian Jinhuyuan Eco-agriculture Co, Ltd, Shaowu, 354099, China
6Dehua Ginger Industry Research Institute, Quanzhou, 362500, China
7Institut de la Recherche Interdisciplinaire de Toulouse, Toulouse, 31300, France
Correspondence: Xu XuHan, Institute of Horticultural Biotechnology, Fujian Agriculture and Forestry University, Fuzhou, Jinan PhytoRTD Eco-Engineering Co. Ltd, Jinan, Dezhou PhytoRTD Ecology Co. Ltd, Dezhou, 253076, China
Received: January 22, 2022 | Published: February 3, 2022
Citation: Wang S, Ban J, Gan Y, et al. Advanced oxidation inhibits microorganisms enabling differential plant and soil sterilization and showing soil ecological restoration potential. Horticult Int J. 2022;6(1):23-26. DOI: 10.15406/hij.2022.06.00237
Advanced oxidation technology is characterized by the generation of hydroxyl radicals (•OH) with higher oxidizing power. In the present work, explants of Polygonatumcyrtonema, Chinese rose and ginger and the microorganisms in the rhizospheresin Fuzhou, China, were treated with advanced oxidations and the disinfection effects were checked by microbe colony development in the in vitro culture media. The results showed that with different Fenton reagent concentrations of FeSO4 and ratios with H2O2 and the time lengths of reaction caused different effects to the explants as well as to the microbes, in which significant disinfection effects were found on the microorganisms at a wide range. Thus, Fenton advanced oxidation technology can be applied to plant in vitro culture and soil-bound microorganism that opens a time window for biotech intervention to the soil as well as ecological restoration.
Keywords: fenton, advanced oxidation, sterilization, ecological restoration, soil, microorganisms
The Fenton reaction was discovered by H.J.H. Fenton in 18941 and he reported that H2O2 could be activated by ferrous (Fe2+) salts to oxidize tartaric acid.1 As an advanced oxidation technology, Fenton reagent can not only directly mineralize organic matter into CO2and H2O, which are harmless to the environment, but more importantly, its composition is also harmless to the environment, and the operation is simple.2,3 In the recent past, Fenton reaction was efficiently utilized in wastewater treatment process for the removal of many hazardous organics from wastewater.4,5
Advanced oxidation technology is characterized by the generation of hydroxyl radicals (•OH) with higher oxidizing power. Under the reaction conditions such as catalysts, macromolecular organic matter is oxidized into small molecular substances, and macromolecular organic substances of soil or in other types of media are oxidized into small molecular substances, which also has damage to living cells and virus. The use of advanced oxidation in ecological protection and biotechnology has not been developed.
In the present work, Fenton's advanced catalytic oxidation was used to treat plant tissues and soil microorganisms to experimentally analyze its applications in explant disinfection in vitro and the potential for ecological restoration.
Materials
Chinese rose stems, Polygonatumcyrtonema tubers and Ginger tubers collected from the cultivation field of Fujian Agriculture and Forestry University(Figure 1)were segmented in 10-20 mm.

Figure 1 Plant materials before processing.
A) Stem segments of Chinese rose
B) P. cyrtonema tuber segments
C) Ginger tuber segments.
Thesoil samplesbound to the roots of Chinese rose, P. cyrtonema, Gingerplants were collected from the cultivation field of Fujian Agriculture and Forestry University,China (Figure 2).The soil sampling was made by cutting soil vertically to expose the vertical surface at 10 cm depth from the ground, and the effluents from the surfaces at 10 cm, 20 cm and 30 cm apart from the plant roots were collected and transferred to the culture media. Each replicate contained 15 to 20 samples.

Figure 2 Soil sampled in the cultivation field in Fujian Agriculture and Forestry University, a superficial view showing the friable mixture of loess and red clay, pH 6-7.
High pressure filter paper, LB, PDA solid medium and liquid medium, sterile water were used for sterilization and infiltration of solutions.
Fenton's reagent, containedH2O2, concentration of 3%, 6%, 9%, 12%, FeSO4solution (molar concentration 0.88mol/L, 24.5% w/v). FeSO4solution was adapted according to the molar mass ratio of 3%(w/v) H2O2.
Methods
Fenton advanced oxidation for plant disinfection
The stem and tuber segments of the plants were washed for 5 min, 3 times, and subjected to 75% alcohol water solution for 30 seconds with constant rotation and rewashed 3 times in autoclave sterilized water. The FeSO4 solutions were in different proportions of Fenton's reagent with FeSO4:H2O2 molar mass ratios 1:1, 1:2, 1:3, 1:4, respectively. The treatments were performed as following:
Treatment 1: H2O2 and FeSO4 solutions were mixed, the explant segments were then submerged in the mixed solution for 15 min reaction. The explants were then washed with autoclave sterilized water 3 times before in vitro culture.
Treatment 2: the explant segments were submerged in the FeSO4 solution (unfiltered) for 10 minutes, then mixed in a H2O2 solution, reacted for 15 minutes, then washed for culture.
Treatment 3: the explant segments were submerged in previously filtered FeSO4 solution for 10 minutes, then mixed in the H2O2 solution for 15 min reaction, then washed for culture.
Control group: the explant segments were only treated in 3% H2O2 solution.
For in vitroculture, the above explant segments were dried with autoclave sterilized filter paper, and separately cultured on solidified MS medium (Figure 3). Disinfection/contamination status was observed after24h, 48h, 72h, 96h and 120h inculture at 28°C.
Figure 3 In vitro cultured samples.
A) Rose stem segment
B) P. cyrtonema tuber segment
C) Ginger tuber segment
D) Soil sample coated plate.
Fenton advance oxidation for rhizosphere microbe disinfection
Soil samples of the above plant rhizospheres at 10 cm, 20 cm, and 30 cm distances from the plantswere collected and incubated in solidified LB and PDA media in dark at 28°C for 12 hours. After microbe colonies developed, the colonies were recovered to the same but liquid media to justifiedthe microbe mixture concentration to the same OD600. The same Fenton solutions as used for the plant segments were equally applied to the microbes. Briefly, previously filtered ferrous sulfate solutions were mixed with microbe solutions and then mixed with hydrogen peroxide solution with the ratios 1:1, 1:2, 1:3, 1:4, respectively (Table 1). After shaking for 15 min, the microbes were recovered from centrifugation pellets, washed and cultured in solidified LB and PDA media in dark at 28°C for 12 h.
|
Fenton Proportion |
FeSO4 (0.88M) |
H2O2 (3%) |
|
1:1 |
2.25ml |
2.25ml |
|
1:2 |
1.5ml |
3ml |
|
1:3 |
1.125ml |
3.375ml |
|
1:4 |
0.9ml |
3.6ml |
Table 1 Different ratios of Fenton reagents for optimization
5 ml as final reaction volume.
Micrographswere taken in different time points of culture to record the development of the microbe colonies.
Optimization of advanced oxidation on plant-bound microbe disinfection with Fenton reaction
Through different treatments of Fenton's reagent, it was found that the disinfection effect of directly mixed ferrous sulfate and hydrogen peroxide solution was poor, and the stem segments of explants, such as rose segments, were all contaminated after 72 hours (Table 2). When the materials were first immersed in ferrous sulfate solution and then in the hydrogen peroxide solution, the disinfection effect as checked after 72h of culture was better than that with the directly mixed reagent. After the ferrous sulfate was filtered, the disinfection effect became better than that of the unfiltered, and the material pollution rate was 0 when FeSO4:H2O2=1:4 checked after 72h of culture. Thus, after filtering the ferrous sulfate solution with a 0.33μmliquid filter, the disinfection effect was better than that without filtering. Using ferrous sulfate (after filtration): hydrogen peroxide 1:4 as a disinfectant, the disinfection effect was better than CK (3% H2O2) and other groups.
|
Fenton |
|
Plant Material Contamination Percentage% |
|
|
|
|
|||||
|
FeSO4:H2O2 |
Process 1 |
Process 2 |
Process 3 |
||||||||
|
(direct mixing) |
|
(unfiltered,post-blended) |
(filtered, post-mixed) |
||||||||
|
Time/h |
CK(0:1) |
1:1 |
1:2 |
1:3 |
1:4 |
1:1 |
1:2 |
1:3 |
1:4 |
1:2 |
1:4 |
|
24 |
0 |
25 |
25 |
25 |
25 |
0 |
0 |
0 |
0 |
0 |
0 |
|
48 |
25 |
100 |
75 |
25 |
50 |
0 |
20 |
29 |
71 |
0 |
0 |
|
72 |
75 |
100 |
100 |
100 |
100 |
50 |
40 |
70 |
100 |
33 |
0 |
Table 2 Disinfection effect of different composition and methods of Fenton reagent
The Fenton prepared with filtered FeSO4showed no contamination of the plant material within 24 hours (Table 3). At the same time, when the ratio was 1:4, the contamination rate of plant samples within 72 hours was 0, and the disinfection situation was better than the control and other groups, which confirmed the previous results.
|
Fenton |
Plant Material Contamination Percentage% |
||||||||||||||
|
FeSO4:H2O2 |
Chinese rose |
|
P. cyrtonema |
Ginger |
|||||||||||
|
Time/h |
CK |
1:1 |
1:2 |
1:3 |
1:4 |
CK |
1:1 |
1:2 |
1:3 |
1:4 |
CK |
1:1 |
1:2 |
1:3 |
1:4 |
|
24 |
0 |
0 |
0 |
0 |
0 |
0 |
0 |
0 |
0 |
0 |
0 |
0 |
0 |
0 |
0 |
|
48 |
15 |
47 |
13 |
13 |
0 |
60 |
7 |
0 |
0 |
0 |
0 |
0 |
0 |
0 |
0 |
|
72 |
30 |
73 |
60 |
60 |
0 |
80 |
27 |
0 |
0 |
0 |
6 |
0 |
0 |
0 |
0 |
|
96 |
45 |
93 |
73 |
73 |
0 |
87 |
27 |
13 |
0 |
0 |
6 |
0 |
0 |
0 |
0 |
|
120 |
45 |
93 |
80 |
80 |
0 |
87 |
47 |
13 |
0 |
0 |
13 |
13 |
0 |
0 |
0 |
Table 3 Contamination of different materials treated with different ratios of Fenton reagent
Over time, low-ratio (FeSO4:H2O2=1:1, 1:2, 1:3) disinfectant sterilized materials all appeared with varying degrees of contamination, high ratio disinfectantFeSO4:H2O2=1:4 treatment showed colony formation within 96h, thus exhibited higher disinfection capacity.
The stem explants of Rose were larger and carriedmore bacteria, and the disinfection effect was not as efficient as that of internal tissue blocks such as P. cyrtonemaand ginger tubers. The effect of Fenton disinfectant thus showed differences for different explants, but the ratio of 1:4 showed always the best disinfection effect for different materials.
Prolonged reaction time was found harmful to the treated explants due to plant tissue browning, whereas the microbe colonies were still able to survive.
Optimization of advanced oxidation on soil-bound microbe disinfection with Fenton reaction
Based on the previous disinfection with plant samples attached with microbes, the same methodology was applied to the soil bound microorganisms in the corresponding plant species at the rhizosphere at different distances form the plants. The filtrated ferrous sulfate solution was used to treat microbes and mix with 3% hydrogen peroxide at the 1:4 ratio as previous used. Autoclaved water was used as negative control and the microbe solution without any treatment with ferrous sulfate solution or hydrogen peroxide was used as positive control.
As checked after 48h of culture (Table 4, Figure 4,5), the number of the soil microbe colonies decreased with the increase of Fenton ratio, indicating that the higher the ratio of Fenton reagent, the better the disinfection effect, which was consistent with the previous results obtained from plant-bound microorganism disinfection.
|
Fenton |
Colony number of groups |
|
|||
|
FeSO4:H2O2 |
soil sample |
||||
|
Time/h |
CK |
1:1 |
1:2 |
1:3 |
1:4 |
|
24 |
4 |
2 |
0 |
0 |
0 |
|
48 |
17 |
7 |
4 |
3 |
1 |
Table 4 Colony formation of soil samples treated with different ratios of Fenton reagent

Figure 4 Fenton based advanced oxidation for soil-bound rhizospheral microorganism disinfection, observed on 0 h (A, CK), 24h (B) and 48h (C) after culture in MS media. Note the optimized Fenton disinfection showed no colony development (upper left No. 4 on the petri dish).

Figure 5 Fenton based advanced oxidation for soil-bound rhizospheral microorganism disinfection, observed on 20h after culture in PDA and LB media.
L: LB medium recovered microbe mixture originally sampled from the rhizosphere soil.
P: PDA medium recovered microbe mixture originally sampled from the rhizosphere soil.
Positive control groups developed smear colonies (up right part of the peri dish).
Pollution treatment, environment restoration and bio-agro-horticulture co-development is the main concern for land ecosystem and people,6,7 in which various efficient tools need to be developed. Plant and microorganism form a united ecosystem in the evolution in normal various conditions and particular stress conditions, e.g. salt conditions worldwide.8To protect crops and ecosystem from hazardous wastes and harmful microbes, oxygen-based disinfection chemicals are more environment friendly than chlorine-based ones in the advanced oxidation applications due to the release of O or Cl element to the environment.
The Fenton method is a deep oxidation technique that utilizes the chain reaction between Fe2+and H2O2 to catalyze the generation of OH radicals. And OH free radicals have strong oxidizing properties and can oxidize various toxic and refractory organic compounds to achieve the purpose of removing pollutants.9 It is especially more efficient for the oxidation treatment of organic wastewater such as landfill leachate that is difficult to biodegrade or that general chemical oxidation is ineffective. The main influencing factors of landfill leachate treatment by Fenton method are pH, temperature, dosage of H2O2 and dosage of iron salt.4,10,11 Hydrogen peroxide is an inorganic compound. The aqueous solution is commonly suitable for medical wound disinfection, environmental disinfection and food disinfection. Under normal circumstances, it will slowly decompose into water and oxygen, but the decomposition rate is extremely slow. The way to speed up the reaction is to add a catalyst or irradiate with short-wave rays, e.g., UV. The combination of Fe2+and H2O2 is technically called Fenton's reagent. It can effectively oxidize and degrade organic pollutants in wastewater, and its essence is that H2O2 produces OH with high reactivity under the catalysis ofFe2+. In the present work, the ratio of Fe2+and H2O2 was optimized for biological materials, and Fenton reactions showed a highly efficient disinfection and exhibited a large range for differential disinfection depths both for plants and for microorganisms.As shown in the present work, filtered FeSO4,prefeed of the FeSO4 to the target samples and high ratio of FeSO4, e.g., 4:1to H2O2, is more efficient as the modified Fenton reagent, which is functional in the present tested plant species, explant organs and the soil microbes, and is expected to function in other plants and soil type.
Thus,Fenton advanced oxidation technology is expected to open a time window for biotech intervention to the soil. Since decomposition of harmful maters in the soil into small molecule mass for further decomposition by microbes in the soil is also known of the advanced oxidation, the present technology showed soil ecological restoration potential besides the disinfection applications in the in vitro culture system.
Shanshan Wang and Jingjie Ban work for in vitro culture and analysis. Yu Gan conducted the field sampling and in vitro culture. Jianming Zhu, ZhikangJiangandKexuan Zhang joined the investigations. Yuling Lin, RongfangGuo, Zhongxiong Lai and XuXuHan conceived the study and design the experiments. Shanshan Wang prepared the original draft of this paper. XuXuHan revised the paper. All authors have read and approved the final version
This work was funded by the Plateau Discipline Construction Fund Project of Fujian Province (No.102/71201801101), Minjiang Scholars Award Program of Fujiang Province (No. MJJZ13-003), Identification of the germplasm resources and rapid breeding of high-quality seedlings of P. cyrtonema in Fujian Province (No.102/KH200373A).
All the authors declare that they have no competing interests.

©2022 Wang, et al. This is an open access article distributed under the terms of the, which permits unrestricted use, distribution, and build upon your work non-commercially.